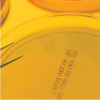

保濕

Hydroplex HHG保濕因子
增加肌膚保水度與賦予彈性。

維生素E維晶纖維素
將維生素E包覆於彈性囊球中。可於更新角質過程中釋放保濕和抗氧化因子,更新肌膚的同時,使活性成分更容易被吸收。

鹽角藻萃取
使肌膚保濕,進而使肌膚維持保水狀態。

鎖水磁石
新一代長效保濕成份.有效防上肌膚水份流失。

尿囊素
安撫、舒緩並潤澤肌膚。

玻尿酸
保濕、維持肌膚彈性,使皮膚光滑水嫩。

人蔘多醣體
保濕、活膚,保持肌膚彈性。

膠質白金微粒
抗氧化

Smartvector UV C-E
法國COLETICA 實驗室研發,以太平洋鮭魚DNA 微脂囊包覆維他命C、E,長時間釋放,減緩紫外線對肌膚影響。

神經醯胺
皮膚天然水分屏障的必要成分。能協助肌膚鎖住水分,防止水分蒸發,並達到保濕,防止養份流失的 作用,使肌膚維持柔軟平滑,具彈性及張力。

角鯊烯

維生素原B5
強效保濕,且與肌膚皮脂膜相近,易於吸收滲透及浸潤肌膚表面的角質層,使肌膚柔軟,有效預防肌膚粗燥現象。